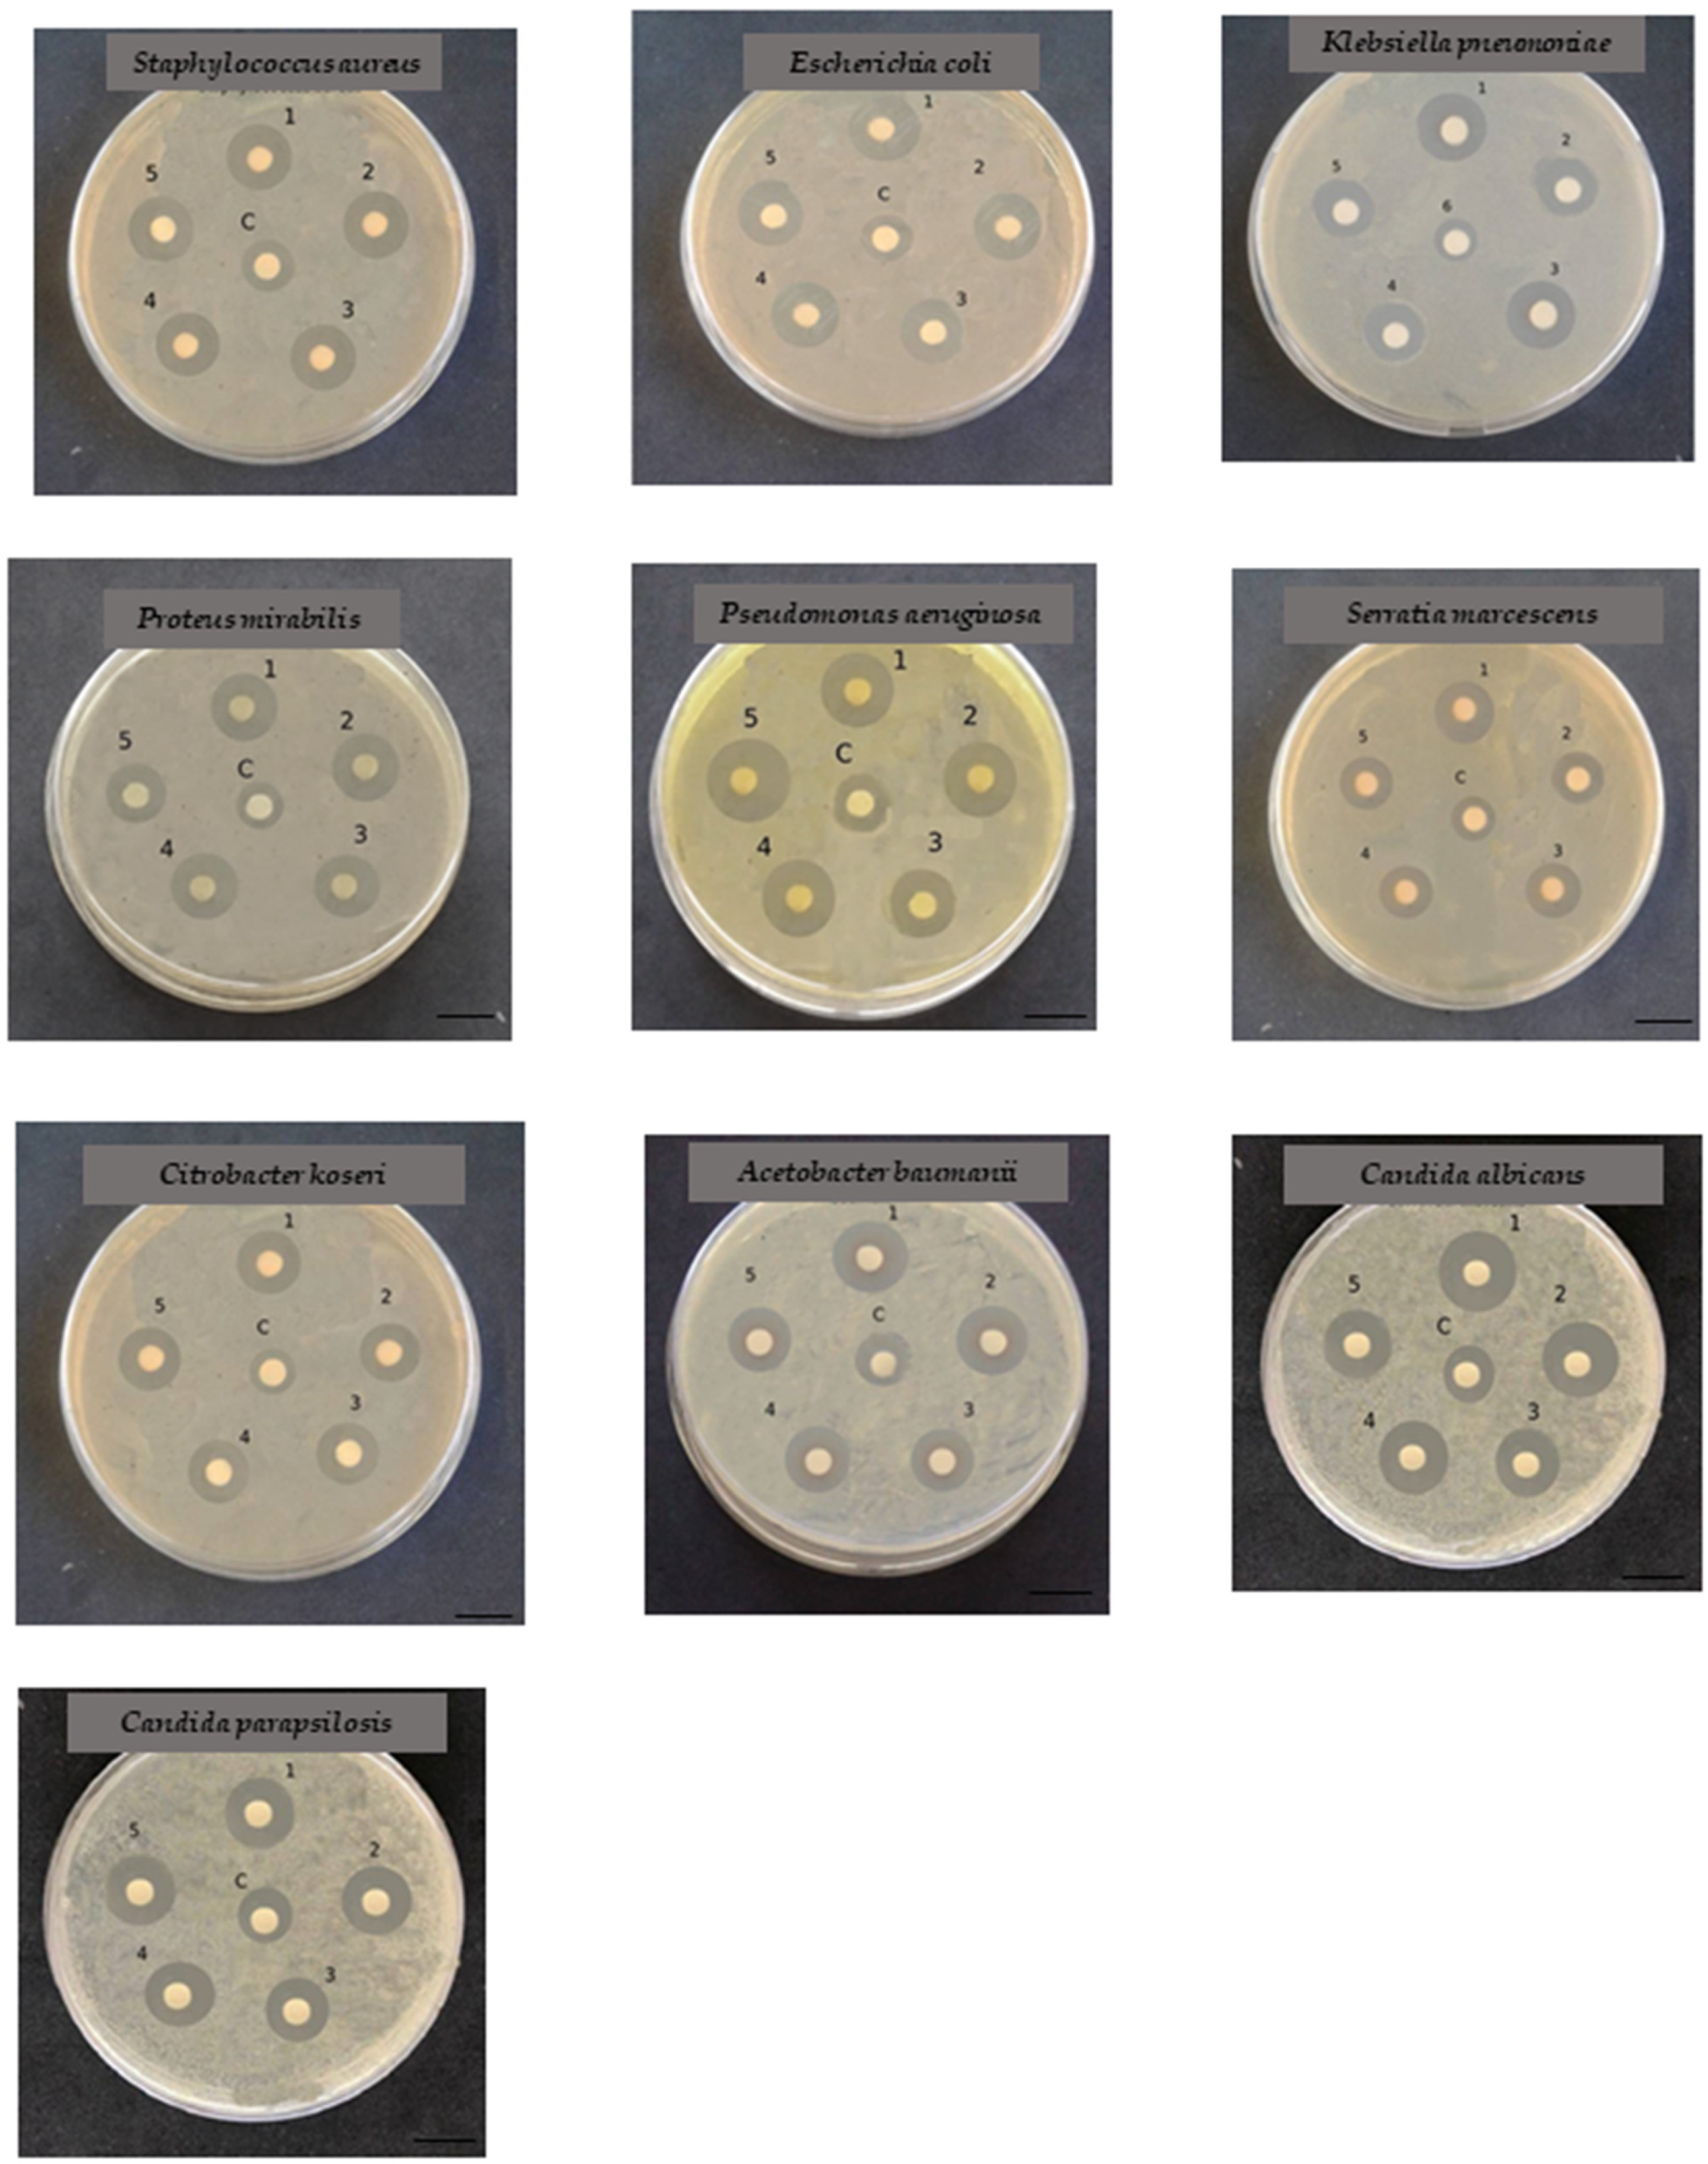
Marinedrugs 22 00089 g006

Synthesis of Bioactive Nickel Nanoparticles Using Bacterial Strains from an Antarctic Consortium
Abstract
1. Introduction
2. Results and Discussion
2.1. Bacterial Synthesis of Nickel (Ni) Nanoparticles
2.2. X-ray Diffraction (XRD) and Fourier Transform Infrared (FTIR) Spectroscopic Analysis
- -
- The observed diffraction peaks of Marinomonas sp. ef1 (Figure 2A) were at 30.1°, 44.82° 53.5°, 62.6° and 73.1°, attributed to (100), (102), (110), (200), and (202) planes of NiSNPs (ICDD 01-075-0613).
- -
- The peaks from Rhodococcus sp. ef1 display distinct diffraction peaks at 31.21°, 34.9°, 47.92°, 53.25°, 63.11°, 73.27°, attributed to (100), (101), (102), (110), (200), and (202) planes of NiSNPs (JCPDS reference 010750613).
- -
- XRD pattern of Pseudomonas sp. ef1 synthesized NiS NPs showed peaks at 31.11°, 34.92°, 47.93°, 53.40°, 63.11° were attributed to (100), (101), (102), (110) and (200) planes of NiSNPs (JCPDS2-1280).
- -
- Brevundimonas sp. ef1 showed formation of nanocrystalline peaks at 31.21°, 34.9°, 47.92°, 53.25° attributed to (100), (101), (102), (110), (200) and (202) planes of NiSNPs (JCPDS card nos: 2-1280).
2.3. Dynamic Light Scattering (DLS) Analysis of Bacterial NiSNPs
2.4. Transmission Electron Microscopy (TEM) Analysis
2.5. Antibacterial and Antifungal Activity of NiSNPs
3. Materials and Methods
3.1. Cultures and Chemicals
3.2. Biosynthesis of NiSNPs
3.3. Extraction and Purification of NiSNPs
3.4. Characterization of NiSNPs
3.5. Assessment of Antibacterial Properties
3.5.1. Bacteria Strains Preparation
3.5.2. In Vitro Antibacterial Susceptibility Test
Kirby–Bauer Disk Diffusion Susceptibility Test
Minimum Inhibitory Concentration (MIC), Minimum Bactericidal (MBC) and Minimum Fungicidal (MFC) Concentration Evaluation
4. Conclusions
Supplementary Materials
Author Contributions
Funding
Institutional Review Board Statement
Data Availability Statement
Acknowledgments
Conflicts of Interest
References
- Ramasamy, K.P.; Mahawar, L.; Rajasabapathy, R.; Rajeshwari, K.; Miceli, C.; Pucciarelli, S. Comprehensive insights on environmental adaptation strategies in Antarctic bacteria and biotechnological applications of cold adapted molecules. Front. Microbiol. 2023, 14, 1197797. [Google Scholar] [CrossRef]
- Grigore, M.E.; Biscu, E.R.; Holban, A.M.; Gestal, M.C.; Grumezescu, A.M. Methods of synthesis, properties and biomedical applications of CuO Nanoparticles. Pharmaceuticals 2016, 9, 75. [Google Scholar] [CrossRef]
- Katwal, R.; Kaur, H.; Sharma, G.; Naushad, M.; Pathania, D. Electrochemical synthesized copper oxide Nanoparticles for enhanced photocatalytic and antimicrobial activity. J. Ind. Eng. Chem. 2015, 31, 173–184. [Google Scholar] [CrossRef]
- Sastry, M.; Ahmad, A.; Khan, M.I.; Kumar, R. Biosynthesis of metal Nanoparticles using fungi and actinomycetes. Curr. Sci. 2003, 85, 162–170. [Google Scholar]
- Mandal, D.; Bolander, M.E.; Mukhopadhyay, D.; Sarkar, G.; Mukherjee, P. The use of microorganisms for the formation of metal nanoparticles and their application. Appl. Microbiol. Biotechnol. 2006, 69, 485–492. [Google Scholar] [CrossRef]
- Hu, J.; Li, L.S.; Yang, W.; Manna, L.; Wang, L.W.; Alivisatos, A.P. Linearly polarized emission from Colloidal Semiconductor Quantum Rods. Science 2001, 5524, 2060–2063. [Google Scholar] [CrossRef]
- Jo, Y.S.; Lee, H.J.; Park, H.M.; Na, T.W.; Jung, J.S.; Min, S.H.; Kim, Y.K.; Yang, S.M. Chemical Vapor Synthesis of Nonagglomerated Nickel Nanoparticles by In-Flight Coating. ACS Omega 2021, 42, 27842–27850. [Google Scholar] [CrossRef] [PubMed]
- Tiwari, S.K.; Paul, B.K. Application of nickel nanoparticles in diffusion bonding of stainless steel surfaces. In Proceedings of the ASME Conference Proceedings, Boston, MA, USA, 31 October–6 November 2008; pp. 441–446. [Google Scholar]
- Li, D.; Komarneni, S. Microwave-assisted polyol process for synthesis of Ni nanoparticles. J. Am. Ceram. Soc. 2006, 89, 1510–1517. [Google Scholar] [CrossRef]
- Couto, G.G.; Klein, J.J.; Schreiner, W.H.; Mosca, D.H.; de Oliveira, A.; Zarbin, A.J.G. Nickel nanoparticles obtained by a modified polyol process: Synthesis, characterization and magnetic properties. J. Colloid Interface Sci. 2007, 311, 461–468. [Google Scholar] [CrossRef] [PubMed]
- Abu-Much, R.; Gedanken, A. Sonochemical synthesis under a magnetic field: Fabrication of nickel and cobalt particles and variation of their physical properties. Chem. Eur. J. 2008, 14, 10115–10122. [Google Scholar] [CrossRef] [PubMed]
- Hou, Y.; Gao, S. Monodisperse nickel nanoparticles prepared from a monosurfactant system and their magnetic properties. J. Mater. Chem. 2003, 13, 1510–1512. [Google Scholar] [CrossRef]
- Zhang, D.; Ni, X.; Zheng, H.; Li, Y.; Zhang, X.; Yang, Z. Synthesis of needle-like nickel nanoparticles in water-in-oil microemulsion. Mater. Lett. 2005, 59, 2011–2014. [Google Scholar] [CrossRef]
- Mittal, A.K.; Chisti, Y.; Banerjee, U.C. Synthesis of metallic nanoparticles using plant extracts. Biotechnol. Adv. 2013, 31, 346–356. [Google Scholar] [CrossRef]
- Vaseghi, Z.; Nematollahzadeh, A.; Tavakoli, O. Green methods for the synthesis of metal nanoparticles using biogenic reducing agents: A review. Rev. Chem. Eng. 2017, 34, 529–559. [Google Scholar] [CrossRef]
- Mozzicafreddo, M.; Pucciarelli, S.; Swart, E.C.; Piersanti, A.; Emmerich, C.; Migliorelli, G.; Ballarini, P.; Miceli, C. The macronuclear genome of the Antarctic psychrophilic marine ciliate Euplotes focardii reveals new insights on molecular cold adaptation. Sci. Rep. 2021, 11, 18782. [Google Scholar] [CrossRef]
- Pucciarelli, S.; Devaraj, R.R.; Mancini, A.; Ballarini, P.; Castelli, M.; Schrallhammer, M.; Petroni, G.; Miceli, C. Microbial Consortium Associated with the Antarctic Marine Ciliate Euplotes focardii: An Investigation from Genomic Sequences. Microb. Ecol. 2015, 70, 484–497. [Google Scholar] [CrossRef] [PubMed]
- Ramasamy, K.P.; Telatin, A.; Mozzicafreddo, M.; Miceli, C.; Pucciarelli, S. Draft Genome Sequence of a New Pseudomonas sp. Strain, ef1, Associated with the Psychrophilic Antarctic Ciliate Euplotes focardii. Microbiol. Resour. Announc. 2019, 8, e00867-19. [Google Scholar] [CrossRef] [PubMed]
- John, M.S.; Nagoth, J.A.; Ramasamy, K.P.; Mancini, A.; Giuli, G.; Miceli, C.; Pucciarelli, S. Synthesis of Bioactive Silver Nanoparticles Using New Bacterial Strains from an Antarctic Consortium. Mar. Drugs 2022, 20, 558. [Google Scholar] [CrossRef]
- John, M.S.; Nagoth, J.A.; Zannotti, M.; Giovannetti, R.; Mancini, A.; Ramasamy, K.P.; Miceli, C.; Pucciarelli, S. Biogenic Synthesis of Copper Nanoparticles Using Bacterial Strains Isolated from an Antarctic Consortium Associated to a Psychrophilic Marine Ciliate: Characterization and Potential Application as Antimicrobial Agents. Mar. Drugs 2021, 19, 263. [Google Scholar] [CrossRef]
- John, M.S.; Nagoth, J.A.; Ramasamy, K.P.; Ballarini, P.; Mozzicafreddo, M.; Mancini, A.; Telatin, A.; Liò, P.; Giuli, G.; Natalello, A.; et al. Horizontal gene transfer and silver nanoparticles production in a new Marinomonas strain isolated from the Antarctic psychrophilic ciliate Euplotes focardii. Sci. Rep. 2020, 10, 10218. [Google Scholar] [CrossRef]
- John, M.S.; Nagoth, J.A.; Ramasamy, K.P.; Mancini, A.; Giuli, G.; Natalello, A.; Ballarini, P.; Miceli, C.; Pucciarelli, S. Synthesis of Bioactive Silver Nanoparticles by a Pseudomonas Strain Associated with the Antarctic Psychrophilic Protozoon Euplotes focardii. Mar. Drugs 2020, 18, 38. [Google Scholar] [CrossRef] [PubMed]
- Zannotti, M.; Ramasamy, K.P.; Loggi, V.; Vassallo, A.; Pucciarelli, S.; Giovannetti, R. Hydrocarbon degradation strategy and pyoverdine production using the salt tolerant Antarctic bacterium Marinomonas sp. ef1. RSC Adv. 2023, 13, 19276–19285. [Google Scholar] [CrossRef] [PubMed]
- Mangiagalli, M.; Lapi, M.; Maione, S.; Orlando, M.; Brocca, S.; Pesce, A.; Barbiroli, A.; Camilloni, C.; Pucciarelli, S.; Lotti, M.; et al. The co-existence of cold activity and thermal stability in an Antarctic GH42 β-galactosidase relies on its hexameric quaternary arrangement. FEBS J. 2021, 288, 546–565. [Google Scholar] [CrossRef] [PubMed]
- Orlando, M.; Pucciarelli, S.; Lotti, M. Endolysins from Antarctic Pseudomonas Display Lysozyme Activity at Low Temperature. Mar. Drugs 2020, 18, 579. [Google Scholar] [CrossRef] [PubMed]
- Sathyavathi, S.; Manjula, A.; Rajendhran, J.; Gunasekaran, P. Extracellular synthesis and characterization of nickel oxide nanoparticles from Microbacterium sp. MRS-1 towards bioremediation of nickel electroplating industrial effluent. Bioresour. Technol. 2014, 165, 270–273. [Google Scholar] [CrossRef] [PubMed]
- Hussein, M.Z.; Azmin, W.H.; Mustafa, M.; Yahaya, A.H. Bacillus cereus as a biotemplating agent for the synthesis of zinc oxide with raspberry- and plate-like structures. J. Inorg. Biochem. 2009, 103, 1145–1150. [Google Scholar] [CrossRef]
- Thangwane, C.S.; Xaba, T.; Moloto, M.J. The formation of the mixed morphology of nickel sulfide nanoparticles derived from substituted benzimidazole dithiocarbamate nickel (ii) complexes. Chalcogenide Lett. 2017, 14, 407–417. [Google Scholar]
- Mallikarjuna, K.; Narasimha, G.; Dillip, G.R.; Praveen, B.; Shreedhar, B.; Sreelakshmi, C.; Reddy, B.P.D. Green synthesis of silver nanoparticles using Ocimum leaf extract and their characterization. Dig. J. Nanomater. Biostruct. 2011, 6, 181–186. [Google Scholar]
- Sathyavathi, R.; Krishna, N.B.; Rao, S.V.; Saritha, R.; Rao, D.N. Biosynthesis of silver nanoparticles using Coriandrum sativum leaf extract and their application in non-linear optics. Adv. Sci. Lett. 2010, 3, 138–143. [Google Scholar] [CrossRef]
- Govindasamy Rajakumar, G.R.; Rahuman, A.A.; Kanayairam Velayutham, K.V.; Jeyaraman Ramyadevi, J.R.; Kadarkaraithangam Jeyasubramanian, K.J.; Arumugam Marikani, A.M.; Gandhi Elango, G.E.; Chinnaperumal Kamaraj, C.K. Novel and simple approach using synthesized nickel nanoparticles to control blood-sucking parasites. Vet. Parasitol. 2013, 191, 332–339. [Google Scholar] [CrossRef]
- Wang, X.S.; Liu XWen LZhou YJiang, Y.; Li, Z. Comparison of basic dye crystal violet removal from aqueous solution by low-cost biosorbents. Sep. Sci. Technol. 2008, 43, 3712–3731. [Google Scholar] [CrossRef]
- Pandian, C.J.; Palanivel, R.; Dhanasekaran, S. Screening Antimicrobial Activity of Nickel nanoparticles Synthesized Using Ocimum sanctum Leaf Extract. J. NPs 2016, 2016, 4694367. [Google Scholar]
- Mancini, A.; Pucciarelli, S. Antibiotic activity of the antioxidant drink effective Microorganism-X (EM-X) extracts against common nosocomial pathogens: An in vitro study. Nat. Prod. Res. 2018, 34, 1575–1580. [Google Scholar] [CrossRef] [PubMed]
- Vassallo, A.; Modi, A.; Quagliariello, A.; Bacci, G.; Faddetta, T.; Gallo, M.; Provenzano, A.; La Barbera, A.; Lombardo, G.; Maggini, V.; et al. Novel Sources of Biodiversity and Biomolecules from Bacteria Isolated from a High Middle Ages Soil Sample in Palermo (Sicily, Italy). Microbiol. Spectr. 2023, 11, e0437422. [Google Scholar] [CrossRef]
- Vanaja, M.; Gnanajobitha, G.; Paulkumar, K.; Rajeshkumar, S.; Malarkodi, C.; Annadurai, G. Phytosynthesis of silver nanoparticles by Cissus quadrangularis: Influence of physicochemical factors. J. Nanostructure Chem. 2013, 3, 17. [Google Scholar] [CrossRef]

| Marinomonas | Rhodococcus | Brevundimonas | Pseudomonas | Bacillus | ||||||
|---|---|---|---|---|---|---|---|---|---|---|
| MIC | MBC | MIC | MBC | MIC | MBC | MIC | MBC | MIC | MBC | |
| Staphylococcus aureus | 12.5 ± 0.2 | 25.0 ± 0.4 | 25.0 ± 0.4 | 25.0 ± 0.4 | 12.5 ± 0.4 | 25.0 ± 0.4 | 25.0 ± 0.4 | 25.0 ± 0.4 | 12.5 ± 0.4 | 12.5 ± 0.4 |
| Escherichia coli | 25 ± 0.4 | 25 ± 0.3 | 12.5 ± 0.1 | 25 ± 0.4 | 25 ± 0.5 | 25 ± 0.2 | 25 ± 0.2 | 25 ± 0.3 | 12.5 ± 0.1 | 12.5 ± 0.4 |
| Klebsiella pneumoniae | 12.5 ± 0.2 | 25 ± 0.2 | 12.5 ± 0.2 | 25 ± 0.5 | 12.5 ± 0.3 | 25 ± 0.4 | 25 ± 0.4 | 25 ± 0.4 | 6.25 ± 0.1 | 12.5 ± 0.3 |
| Pseudomonas aeruginosa | 12.5 ± 0.1 | 12.5 ± 0.2 | 12.5 ± 0.3 | 25 ± 0.43 | 12.5 ± 0.4 | 25 ± 0.2 | 12.5 ± 0.2 | 12.5 ± 0.4 | 12.5 ± 0.2 | 12.5 ± 0.4 |
| Proteus mirabilis | 3.12 ± 0.2 | 6.25 ± 0.4 | 6.25 ± 0.1 | 12.5 ± 0.4 | 12.5 ± 0.2 | 12.5 ± 0.1 | 6.25 ± 0.2 | 12.5 ± 0.3 | 6.25 ± 0.4 | 12.5 ± 0.4 |
| Citrobacter koseri | 6.25 ± 0.2 | 12.5 ± 0.4 | 12.5 ± 0.2 | 12.5 ± 0.3 | 12.50.4 | 25 ± 0.2 | 6.25 ± 0.1 | 12.5 ± 0.4 | 12.5 ± 0.2 | 12.5 ± 0.3 |
| Acinetobacter baumanii | 12.5 ± 0.3 | 12.5 ± 0.2 | 6.25 ± 0.3 | 12.5 ± 0.2 | 12.5 ± 0.3 | 25 ± 0.4 | 12.5 ± 0.3 | 12.5 ± 0.5 | 12.5 ± 0.2 | 12.5 ± 0.1 |
| Serratia marcescens | 6.25 ± 0.2 | 12.5 ± 0.4 | 6.25 ± 0.4 | 12.5 ± 0.2 | 6.25 ± 0.1 | 12.5 ± 0.3 | 12.5 ± 0.4 | 12.5 ± 0.2 | 6.25 ± 0.1 | 12.5 ± 0.4 |
| MIC | MFC | MIC | MFC | MIC | MFC | MIC | MFC | MIC | MFC | |
| Candida albicans | 25 ± 0.4 | 25 ± 0.3 | 12.5 ± 0.5 | 25 ± 0.1 | 12.5 ± 0.4 | 25 ± 0.4 | 25 ± 0.2 | 25 ± 0.4 | 12.5 ± 0.4 | 25 ± 0.2 |
| Candida parapsilosis | 12.5 ± 0.1 | 25 ± 0.4 | 25 ± 0.3 | 25 ± 0.2 | 12.5 ± 0.2 | 25 ± 0.3 | 12.5 ± 0.1 | 25 ± 0.3 | 6.25 ± 0.2 | 12.5 ± 0.3 |
Disclaimer/Publisher’s Note: The statements, opinions and data contained in all publications are solely those of the individual author(s) and contributor(s) and not of MDPI and/or the editor(s). MDPI and/or the editor(s) disclaim responsibility for any injury to people or property resulting from any ideas, methods, instructions or products referred to in the content. |
© 2024 by the authors. Licensee MDPI, Basel, Switzerland. This article is an open access article distributed under the terms and conditions of the Creative Commons Attribution (CC BY) license (https://creativecommons.org/licenses/by/4.0/).
Share and Cite
Nagoth, J.A.; John, M.S.; Ramasamy, K.P.; Mancini, A.; Zannotti, M.; Piras, S.; Giovannetti, R.; Rathnam, L.; Miceli, C.; Biondini, M.C.; et al. Synthesis of Bioactive Nickel Nanoparticles Using Bacterial Strains from an Antarctic Consortium. Mar. Drugs 2024, 22, 89. https://doi.org/10.3390/md22020089
Nagoth JA, John MS, Ramasamy KP, Mancini A, Zannotti M, Piras S, Giovannetti R, Rathnam L, Miceli C, Biondini MC, et al. Synthesis of Bioactive Nickel Nanoparticles Using Bacterial Strains from an Antarctic Consortium. Marine Drugs. 2024; 22(2):89. https://doi.org/10.3390/md22020089
Chicago/Turabian StyleNagoth, Joseph Amruthraj, Maria Sindhura John, Kesava Priyan Ramasamy, Alessio Mancini, Marco Zannotti, Sara Piras, Rita Giovannetti, Lydia Rathnam, Cristina Miceli, Maria Chiara Biondini, and et al. 2024. "Synthesis of Bioactive Nickel Nanoparticles Using Bacterial Strains from an Antarctic Consortium" Marine Drugs 22, no. 2: 89. https://doi.org/10.3390/md22020089
APA StyleNagoth, J. A., John, M. S., Ramasamy, K. P., Mancini, A., Zannotti, M., Piras, S., Giovannetti, R., Rathnam, L., Miceli, C., Biondini, M. C., & Pucciarelli, S. (2024). Synthesis of Bioactive Nickel Nanoparticles Using Bacterial Strains from an Antarctic Consortium. Marine Drugs, 22(2), 89. https://doi.org/10.3390/md22020089

